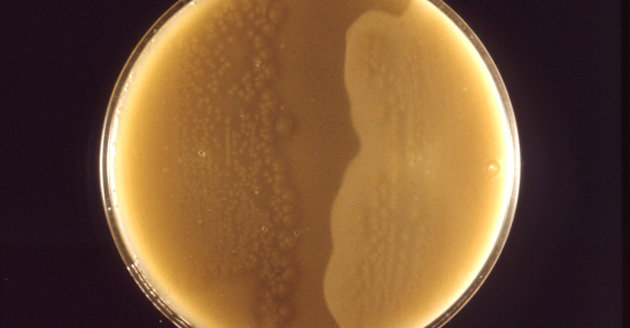

据外国媒体10月8日报道,114年前,纽约贝尔维尤医学院的专家收集了满满一玻璃瓶的细菌。昨天,纽约大学的细菌学家马丁巴索打开了这个瓶子。
瓶里的细菌被确认为“产气荚膜梭菌”,已经沉睡了100多年。巴索和他的团队希望将这种年代久远的古老微生物与他们在人类内脏中找到的细菌进行比较。从1897年到现在,医院学界已经发生了翻天覆地的变化。当时,产气荚膜梭菌能够导致坏疽等感染疾病,而如今这种细菌已经很少使人致病。
(来源:中国日报网 王菁 编辑:杨洁)
 中国日报一周图片精选:6月6日-12日
中国日报一周图片精选:6月6日-12日
 争执
争执
 中国日报一周图片精选:6月6日-12日
中国日报一周图片精选:6月6日-12日
 争执
争执



 民间武装称找到MH17黑匣子 专题" border=0 width="130" height="100" />
民间武装称找到MH17黑匣子 专题" border=0 width="130" height="100" />